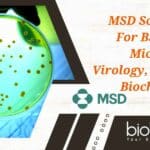
MSD Scientist Job For BSc Biology, Microbiology, Virology, Mol Bio or Biochem, Apply Online MSD Scientist Job

Home Search
biology - search results
If you're not happy with the results, please do another search
UPSC Biology Scientific Officer Job For Biotech, Biochem, Genetics, Microbiology – Apply Online
UPSC Biology Scientific Officer Job For Biotech, Biochem, Genetics, Microbiology - Apply Online
UPSC Biology Scientific Officer Job For Biotech, Biochem, Genetics, Microbiology - Apply...
IIT Kanpur MSc Biology Project Associate Positions Available, Applications Invited
IIT Kanpur MSc Biology Project Associate Positions Available, Applications Invited
IIT Kanpur MSc Biology Project Associate Positions Available, Applications Invited. IIT Kanpur MSc Biology Project...
MSc Biology Project Job at RCB – Online Application Process
MSc Biology Project Job at RCB - Online Application Process
MSc Biology Project Job at RCB - Online Application Process. MSc Biology project opening. Interested...
Freshers Job at Merck – MSc Biotech, Biochem, Mol Bio & Microbiology Apply For...
Freshers Job at Merck - MSc Biotech, Biochem, Mol Bio & Microbiology Apply For Analyst Role
Dear all, we are hiring Analyst (Contract) in our team. Freshers...
ICAR-IARI MSc, PhD Life Sciences, Biotech, Microbiology Project Jobs – Applications Invited
IARI Project Vacancies Latest For MSc PhD Life Sciences, Biotech, Microbiology
IARI Project Vacancies Latest For MSc PhD Life Sciences, Biotech, Microbiology. Walk-in-Interview at ICAR-Indian...
The Nature Conservancy Hiring – MSc Biology / Zoology Project Research Fellow
The Nature Conservancy Hiring The Nature Conservancy, seek a Project Research Fellow to provide scientific and technical support in the project to develop knowledge...
JRF Post Opening @ NIT Rourkela For Non NET- Life Science, Microbiology, Biochemistry Candidates
Biochemistry job opening 2023, Microbiology job opening at Rourkela Looking for a JRF position at NITR check out all the details given the same...
CSIR-NEERI MSc Microbiology / Biotechnology Job – Applications Invited
CSIR-NATIONAL ENVIRONMENTAL ENGINEERING RESEARCH INSTITUTE NEHRU MARG, NAGPUR 440 020 (M.S.) INDIA - invites for the application of Application from eligible & interested candidates...
Freshers Job Alert – Clarivate Content Editor – Clinical Studies Job For Biotech /...
Freshers Biotech Microbiology Job at Clarivate. Clarivate Associate Content Editor - Job For Life Sciences - Fresher Can Apply. MSc microbiology Job. Apply online...
IISER Kolkata Project Assistant Post for MSc in Biotech / Zoology / Molecular biology...
Project Assistant Job at IISER Kolkata for MSc Candidates
Applications are invited for a “Project Assistant” position in DBT funded project in the Dept....
TIFR Junior Research Fellow Job Opening in Cell Biology and Structural Biology
TIFR Hyderabad JRF Job Position of Junior Research Fellow in Cell Biology and Structural Biology at Tata Institute of Fundamental Research Hyderabad
Tata Institute of...
Nalanda Vidyaniketan BSc/MSc Biology Teacher Job With Salary up to Rs 45,000/-pm
Nalanda Vidyaniketan biology teacher job opening 2023, Bachelor's degree in Biology. Master's degree or B.Ed in Biology candidates apply for the post of biology...
Pfizer Microbiology Associate Job Vacancy – Apply Online
Pfizer Microbiology Associate, Pfizer MSc Microbiology Associate Job - Apply Online. Pfizer is hiring candidates for an Associate vacancy. Interested and eligible applicants can...
MSD Scientist Job For BSc Biology, Microbiology, Virology, Mol Bio or Biochem, Apply Online
MSD Scientist Job For BSc - Apply Online
MSD Scientist Job For BSc - Apply Online. MSD Scientist Job For BSc in Biology, Microbiology, Virology,...
SSS-NIBE Bio- Energy Promotion Fellowship JRF Job For Biochem, Biotech & Microbiology Candidates
SSS-NIBE Bio- Energy Promotion Fellowship JRF Job For Biochem, Biotech & Microbiology Candidates
SSS-NIBE Bio- Energy Promotion Fellowship JRF Job For Biochem, Biotech & Microbiology...